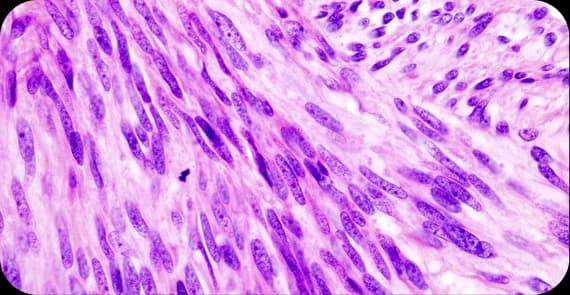
Stromal Tumours

Beyond Conventional Treatment. Grounded in Evidence.
Ovarian cancer is one of the most difficult cancers to catch early. It rarely causes obvious symptoms in the beginning. By the time most women seek care, the disease has already progressed. But a late diagnosis is not the same as no hope. With the right specialist and the right plan, outcomes change.
Dr Tarang Krishna combines clinical oncology with Cancer Healer Therapy, strengthening your body's ability to respond, recover, and rebuild through every stage of treatment.
Ovarian cancer originates in the ovaries, fallopian tubes, or the peritoneum lining the abdominal cavity. The ovaries produce eggs and the hormones oestrogen and progesterone. When cells within or around them mutate and grow uncontrollably, a malignant tumour forms. Because the ovaries sit deep within the pelvis, early tumours cause little discomfort, making awareness and timely evaluation critical.
If you have been experiencing persistent bloating or pelvic discomfort, speak with Dr. Tarang Krishna before dismissing it as something minor.
Accounts for 90% of cases. High-grade serous carcinoma is the most common and aggressive subtype.
Arise from egg-producing cells. More common in younger women and generally more responsive to treatment.
Develop from connective tissue cells within the ovary. Often detected earlier due to hormonal symptoms.
Closely related to epithelial ovarian cancer and treated similarly.
Now considered part of the same disease spectrum as high-grade serous ovarian cancer.
The causes of ovarian cancer are as follows:
Biological & Genetic
Gene mutations
Family history of ovarian, breast, or colorectal cancer
Endometriosis
Early menstruation or late menopause
Long-term hormone replacement therapy post-menopause
Lifestyle & Environmental
Obesity, particularly in postmenopausal women
Smoking
Long-term asbestos exposure
Age
Ovarian cancer symptoms are easy to overlook in the early stages. The signs of ovarian cancer to watch for include:
Persistent bloating that does not resolve
Pelvic or lower abdominal pain
Feeling full quickly or difficulty eating
Frequent or urgent urination
Unexplained fatigue or weight changes
Changes in bowel habits without clear cause
Abnormal vaginal bleeding, particularly post-menopause
Pain during intercourse
Ovarian cyst cancer symptoms closely mimic those of a benign cyst. The key difference is persistence alongside systemic symptoms such as unexplained fatigue or weight loss.
If two or more of these symptoms have lasted beyond three weeks, they need investigation — not monitoring.
Persistent symptoms deserve a specialist's attention, not a wait-and-see approach. Book an evaluation with Dr Tarang Krishna
Pelvic Ultrasound
Blood Tests
CT Scan of abdomen and pelvis
MRI
PET-CT Scan
Diagnostic Laparoscopy
Molecular Testing for targeted therapy eligibility and family risk counselling
Ovarian Cancer Surgery
Chemotherapy
Bevacizumab
Immunotherapy
Hormone Therapy
Cancer Healer Therapy
Ovarian cancer does not follow a single path and it should not be treated with a single protocol.
Every case seen by Dr Tarang Krishna begins with a detailed assessment of tumour biology, surgical history, and molecular markers. For patients already in treatment elsewhere, he offers a focused clinical reassessment not to redo what has been done, but to ensure what comes next is precisely right.
Cancer Healer Therapy works alongside chemotherapy and surgery — not against them. It keeps you stronger going in and more resilient coming out.
Ovarian cancer is a malignancy originating in the ovaries, fallopian tubes, or peritoneum. It is often diagnosed late due to non-specific early symptoms.
Stay informed with the latest in integrative cancer care, wellness tips, and program updates.